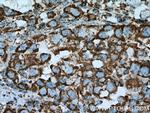
Citrate synthase Antibody in Immunohistochemistry (Paraffin) (IHC (P))

Search
Proteintech
Citrate synthase Polyclonal Antibody
{{$productOrderCtrl.translations['antibody.pdp.commerceCard.promotion.promotions']}}
{{$productOrderCtrl.translations['antibody.pdp.commerceCard.promotion.viewpromo']}}
{{$productOrderCtrl.translations['antibody.pdp.commerceCard.promotion.promocode']}}: {{promo.promoCode}} {{promo.promoTitle}} {{promo.promoDescription}}. {{$productOrderCtrl.translations['antibody.pdp.commerceCard.promotion.learnmore']}}
产品信息
16131-1-AP
种属反应
已发表种属
宿主/亚型
分类
类型
抗原
偶联物
形式
浓度
规格
纯化类型
保存液
内含物
保存条件
运输条件
产品详细信息
This antibody is specific to CS.
Immunogen sequence: EQVSWLSKE WAKRAALPSH VVTMLDNFPT NLHPMSQLSA AVTALNSESN FARAYAQGIS RTKYWELIYE DSMDLIAKLP CVAAKIYRNL YREGSGIGAI DSNLDWSHNF TNMLGYTDHQ FTELTRLYLT IHSDHEGGNV SAHTSHLVGS ALSDPYLSFA AAMNGLAGPL HGLANQEVLV WLTQLQKEVG KDVSDEKLRD YIWNTLNSGR VVPGYGHAVL RKTDPRYTCQ REFALKHLPN DPMFKLVAQL YKIVPNVLLE QGKAKNPWPN VDAHSGVLLQ YYGMTEMNYY TVLFGVSRAL GVLAQLIWSR ALGFPLERPK SMSTEGLMKF VDSKSG (132-466 aa encoded by BC010106)
靶标信息
The protein encoded by this gene is a Krebs tricarboxylic acid cycle enzyme that catalyzes the synthesis of citrate from oxaloacetate and acetyl coenzyme A. The enzyme is found in nearly all cells capable of oxidative metabolism. This protein is nuclear encoded and transported into the mitochondrial matrix, where the mature form is found.
仅用于科研。不用于诊断过程。未经明确授权不得转售。
生物信息学
蛋白别名: Citrate (Si)-synthase; Citrate synthase, mitochondrial; citrate synthetase; unnamed protein product
基因别名: 2610511A05Rik; 9030605P22Rik; Ahl4; BB234005; Cis; CS
UniProt ID: (Human) O75390, (Mouse) Q9CZU6, (Rat) Q8VHF5
Entrez Gene ID: (Human) 1431, (Mouse) 12974, (Rat) 170587